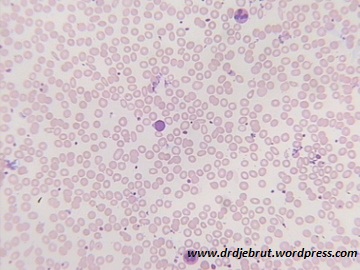

Hapusan Anemia Defisiensi Fe
Gambaran morfologi dari anemia defisiensi besi dapat kita lihat dari hapusan darah di bawah ini. Ukuran eritrosit berbeda-beda cenderung lebih kecil dari normal (mikrositik). Kita lihat juga adanya hipokrom.
Dari pembesaran 1000x dapat kita lihat lebih jelas morfologi dari sel darah merah. Terdapat bentukan eritrosit yang gepeng berbentuk seperti pensil (pencil cells atau cigar cells).
Sedangkan dari pemeriksaan BMP yang perlu dilihat adalah cadangan Fe, dimana pada penderita anemia defisiensi besi cadangan Fe nya negatif. Pada hapusan di bawah bisa kita lihat tidak ada warna kebiruan atau kehijauan yang menandakan cadangan Fe.
Contoh pemeriksaan BMP pada orang normal yang cadangan Fe nya positif
Semoga bermanfaat..